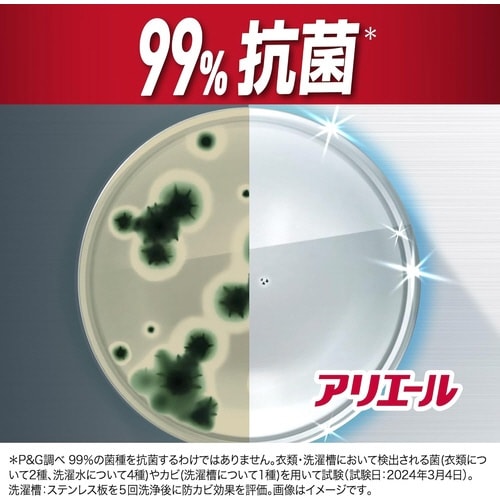
�A���G�[���W�F��

クーポン対応の為購入。ジェルタイプは少量使用時も便利です。
| 商品ラインアップ |
数量
|
販売価格
|
カート |
|---|---|---|---|
|
商品番号:8405-9499
お届け予定日:6月18日(木) お急ぎ便:6月17日(水)
お届け予定日:6月18日(木) お急ぎ便:6月17日(水) ¥668 (税込)
|
1本
|
¥668
(税込)
|
|
|
アリエールジェル部屋干しプラス 本体 700G 295224 1本 商品番号:8405-9505
お届け予定日:6月18日(木) お急ぎ便:6月17日(水)
お届け予定日:6月18日(木) お急ぎ便:6月17日(水) ¥668 (税込)
|
1本
|
¥668
(税込)
|
|
|
アリエールジェル除菌プラス 本体 700G 295293 1本 商品番号:8405-9512
お届け予定日:6月18日(木) お急ぎ便:6月17日(水)
お届け予定日:6月18日(木) お急ぎ便:6月17日(水) ¥668 (税込)
|
1本
|
¥668
(税込)
|
|
|
商品番号:8405-9529
お届け予定日:6月18日(木) お急ぎ便:6月17日(水)
お届け予定日:6月18日(木) お急ぎ便:6月17日(水) ¥668 (税込)
|
1袋
|
¥668
(税込)
|
|
|
アリエールジェル部屋干しプラス 替 625G 309365 1袋 商品番号:8405-9536
お届け予定日:6月18日(木) お急ぎ便:6月17日(水)
お届け予定日:6月18日(木) お急ぎ便:6月17日(水) ¥668 (税込)
|
1袋
|
¥668
(税込)
|
|
|
アリエールジェル除菌プラス 替 625G 309143 1袋 商品番号:8405-9543
お届け予定日:6月18日(木) お急ぎ便:6月17日(水)
お届け予定日:6月18日(木) お急ぎ便:6月17日(水) ¥668 (税込)
|
1袋
|
¥668
(税込)
|
|
|
商品番号:8405-9550
お届け予定日:6月18日(木) お急ぎ便:6月17日(水)
お届け予定日:6月18日(木) お急ぎ便:6月17日(水) ¥980 (税込)
|
1袋
|
¥980
(税込)
|
|
|
アリエールジェル除菌プラス 替 1000G 309082 1袋 商品番号:8405-9567
お届け予定日:6月18日(木) お急ぎ便:6月17日(水)
お届け予定日:6月18日(木) お急ぎ便:6月17日(水) ¥980 (税込)
|
1袋
|
¥980
(税込)
|
|
|
商品番号:8405-9574
お届け予定日:6月18日(木) お急ぎ便:6月17日(水)
お届け予定日:6月18日(木) お急ぎ便:6月17日(水) ¥1,298 (税込)
|
1袋
|
¥1,298
(税込)
|
|
|
アリエールジェル部屋干しプラス 替 1400G 309211 1袋 商品番号:8405-9581
お届け予定日:6月18日(木) お急ぎ便:6月17日(水)
お届け予定日:6月18日(木) お急ぎ便:6月17日(水) ¥1,298 (税込)
|
1袋
|
¥1,298
(税込)
|
|
|
アリエールジェル除菌プラス 替 1400G 309013 1袋 商品番号:8405-9598
お届け予定日:6月18日(木) お急ぎ便:6月17日(水)
お届け予定日:6月18日(木) お急ぎ便:6月17日(水) ¥1,298 (税込)
|
1袋
|
¥1,298
(税込)
|
|
|
商品番号:8405-9604
お届け予定日:6月18日(木) お急ぎ便:6月17日(水)
お届け予定日:6月18日(木) お急ぎ便:6月17日(水) ¥1,504 (税込)
|
1袋
|
¥1,504
(税込)
|
|
|
アリエールジェル部屋干しプラス 替 1720G 309198 1袋 商品番号:8405-9611
お届け予定日:6月18日(木) お急ぎ便:6月17日(水)
お届け予定日:6月18日(木) お急ぎ便:6月17日(水) ¥1,504 (税込)
|
1袋
|
¥1,504
(税込)
|
|
|
アリエールジェル除菌プラス 替 1720G 309037 1袋 商品番号:8405-9628
お届け予定日:6月18日(木) お急ぎ便:6月17日(水)
お届け予定日:6月18日(木) お急ぎ便:6月17日(水) ¥1,504 (税込)
|
1袋
|
¥1,504
(税込)
|
|
共通の商品仕様 (各商品の仕様は、商品詳細ページでご確認ください)
-
星5つ
-
星4つ0件のレビュー
-
星3つ0件のレビュー
-
星2つ0件のレビュー
-
星1つ0件のレビュー